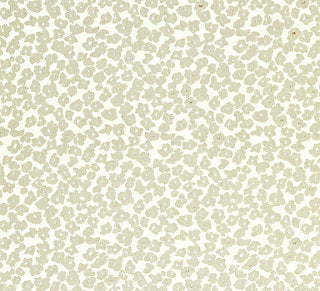
Grey Watkins for Scalamandre:  Oleana GW 0001 16619 Starlight

Scalamandre
Grey Watkins for Scalamandre: Oleana GW 0001 16619 Starlight
Grey Watkins for Scalamandre: Oleana GW 0001 16619 Starlight
Regular price
$387.00 USD
Regular price
$516.00 USD
Sale price
$387.00 USD
Unit price
per
Couldn't load pickup availability
- Grey Watkins - Fabric
- sku: Scalamandre: OLEANA
- Collection: The Flora Collection
- Match: Straight
- Contents: 100% Linen
- Color: Starlight
- Approx Width: 52.5"
- Approx Repeat: V. 37", H. 13"
- Match: Straight
- Drapery
- 2 yard minimum
- All stock fabrics ship within 48 hours
- We will confirm availability upon receipt of your order. If you prefer to check stock prior to placing an order, please contact us with your yardage requirements.
- All products are first quality goods direct from manufacture
- Samples and CFAs available
- Guaranteed lowest prices online!